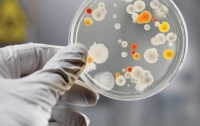
В Харькове появились первые жертвы опасного турецкого вируса

ВСЕ НОВОСТИ
-
 19:16 Здоровье
19:16 Здоровье
Украину атакуют энтеровирусные заболевания, - врач
-
 18:35 Здоровье
18:35 Здоровье
Вирус Коксаки в Украине: врач предупредил о новой тенденции
-
 19:34 Здоровье
19:34 Здоровье
На Днепропетровщине зафиксирован новый опасный вирус
-
22:09 Здоровье
22:09 Здоровье
В Харькове появились первые жертвы опасного турецкого вируса
-
 01:13 Мир
01:13 Мир
Турция борется с вирусом Коксаки
-
 09:45 Здоровье
09:45 Здоровье
Вирус Коксаки: в Украине зафиксирована вспышка болезни
-
 23:25 Здоровье
23:25 Здоровье
В Украине свирепствует вирус Коксаки




